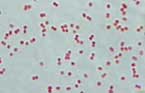
髄膜炎菌性髄膜炎

ヘルスケアカテゴリのアクセスランキング
2018年6月17日のデイリーキーワードランキング
| 1 | コンプライアンス |
| 2 | アンチエイジング |
| 3 | 罹患 |
| 4 | 亀裂 |
| 5 | IADL |
| 6 | 局所 |
| 7 | 器官 |
| 8 | 太陽 |
| 9 | カミングアウト |
| 10 | 拮抗 |
| 11 | 自尊心 |
| 12 | びまん性の |
| 13 | 文化 |
| 14 | 反応 |
| 15 | 欠如 |
| 16 | スクリーニング |
| 17 | 環境 |
| 18 | 胸郭 |
| 19 | ストレス |
| 20 | 拘縮 |
| 21 | アルファルファ |
| 22 | 角膜上皮剥離 |
| 23 | 慢性 |
| 24 | 疾患 |
| 25 | 権利擁護 |
| 26 | 痙攣 |
| 27 | バイアス |
| 28 | たん |
| 29 | う歯 |
| 30 | 胃潰瘍 |
| 31 | 動体視力 |
| 32 | 不穏 |
| 33 | 重複 |
| 34 | モニタリング |
| 35 | 酵素 |
| 36 | 適応 |
| 37 | 仰臥位 |
| 38 | インテーク |
| 39 | リコール |
| 40 | ジェンダー |
| 41 | 潰瘍 |
| 42 | 海綿 |
| 43 | P 値 |
| 44 | 過剰 |
| 45 | 側臥位 |
| 46 | 亢進 |
| 47 | グリセリン |
| 48 | トリグリセライド |
| 49 | 直径 |
| 50 | WBC |
2026年2月4日 05時37分更新(随時更新中)